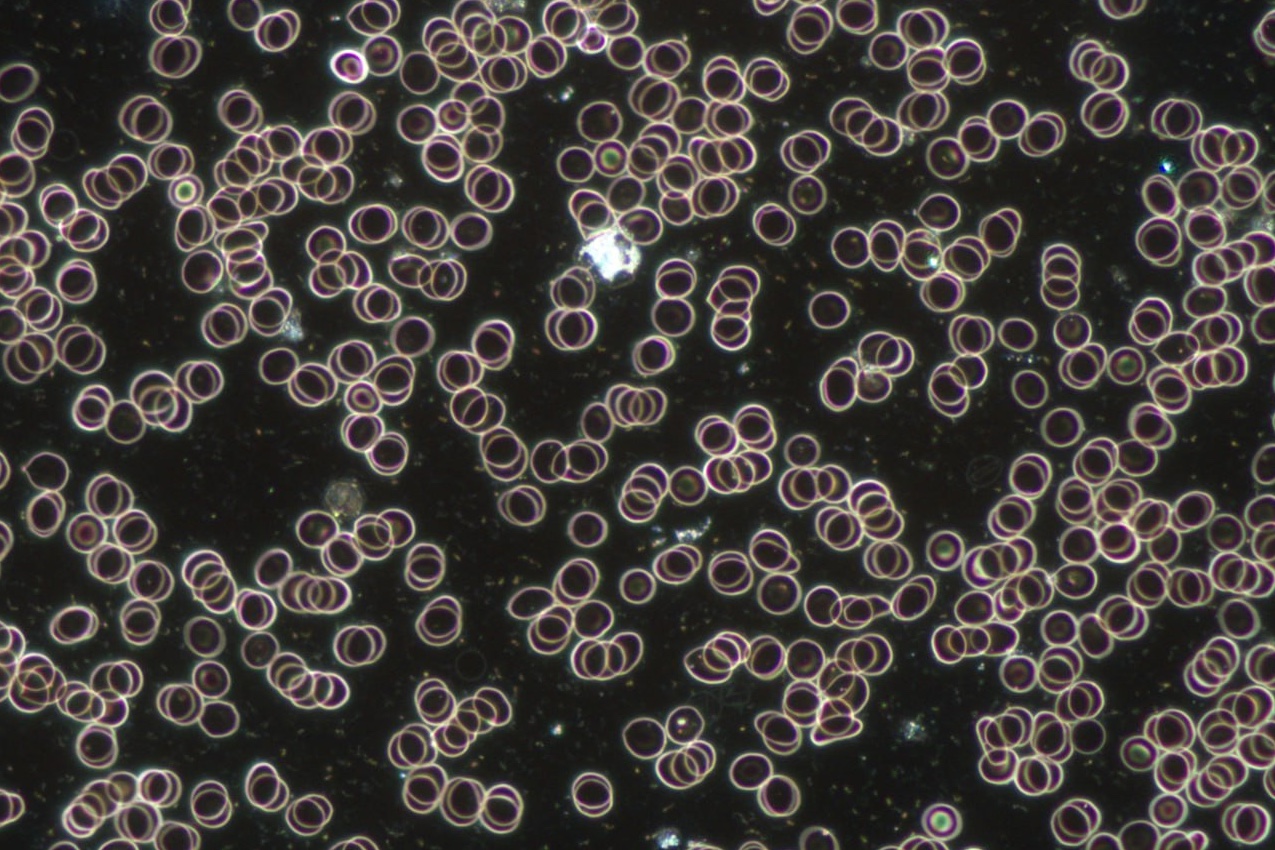
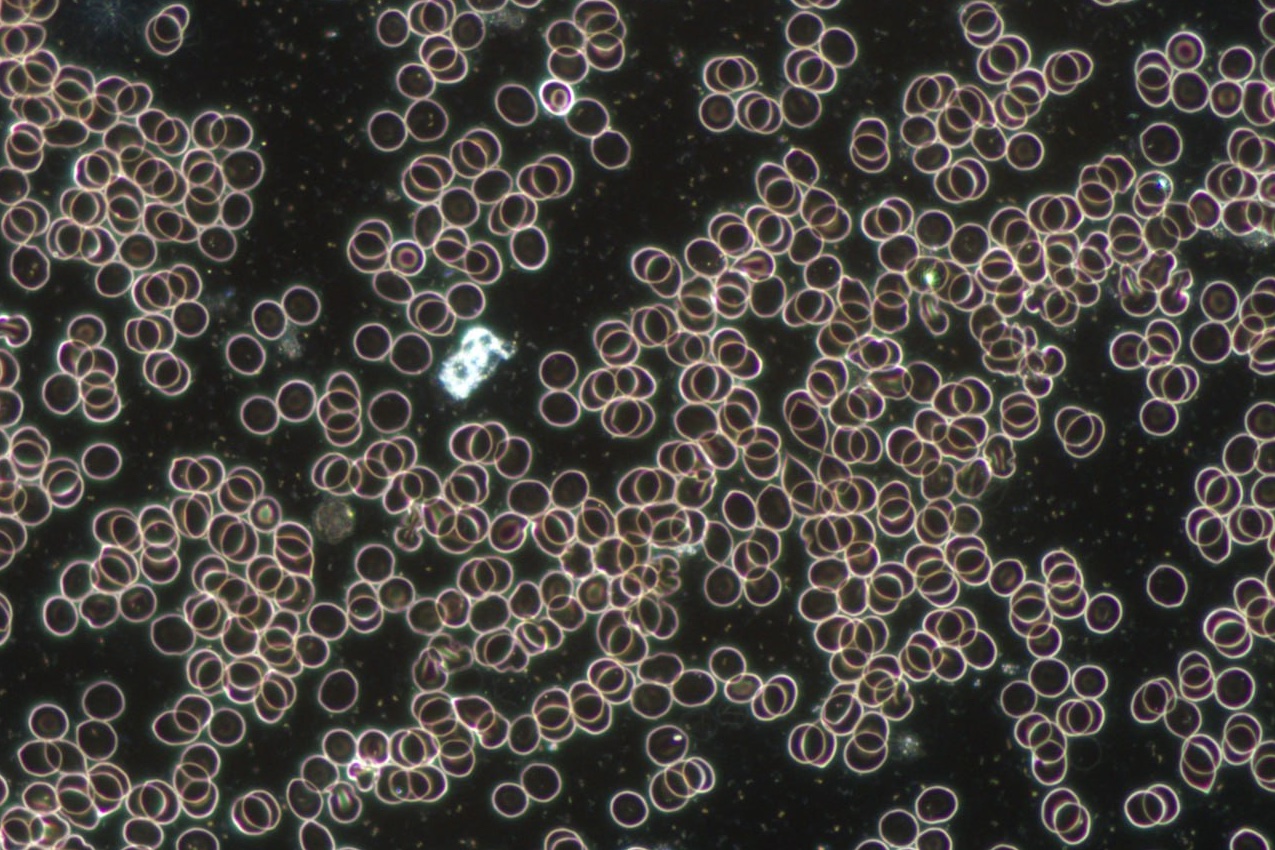

Power Tropfen
MyImpulse
Optimiert die Zellkommunikation
Die MyImpulse Powertropfen sind ein Nahrungsergänzungsmittel auf der Basis von Bio-Agavedicksaft und Holunderbeerenextrakt und enthält die Vitamie B6 und B12. (Ohne E-Stoffe, Zuckerzusätze oder Alkohol!) Während der speziellen Herstellung werden die Tropfen natürlich informiert und können dazu beitragen, dass die Zellen mehr Sauerstoff erhalten und sich die Zellkommunikation optimiert.
Wir wissen von vielen Menschen und aus eigener Erfahrung, dass nach der ersten Einnahme der MyImpulse Tropfen eine Veränderung im Körper wahrnehmbar ist.
Ronald Test vorher
Ronald Test nachher
Ronald Test 10 Min. später
Für wen ist es geeignet?
MyImpulse Power ist die perfekte Lösung für Sportler und Personen mit wenig Energie.
„MyImpulse Power“ bietet Dir eine einzigartige Formel, die speziell entwickelt wurde, um Deine Energie und Deine Leistungsfähigkeit wieder auf den Normalzustand zu heben (100%). Egal, ob Du ein professioneller Sportler bist, regelmäßig ins Fitnessstudio gehst oder einfach nur Deinen aktiven Lebensstil unterstützen möchtest, „MyImpulse Power“ gibt Dir den notwendigen Energieschub, um Deine Ziele zu erreichen.
Vitamin B6 und B12
Vitamin B6 und B12 sind essenzielle Nährstoffe, die unser Körper benötigt, um optimal zu funktionieren. Beide Vitamine spielen eine wichtige Rolle bei der Unterstützung des Nervensystems, der Blutbildung und des Energiestoffwechsels.
Vitamin B6, auch bekannt als Pyridoxin, ist ein wasserlösliches Vitamin, das bei der Synthese von Neurotransmittern und Hämoglobin beteiligt ist. Es unterstützt auch die Aufnahme von Aminosäuren, die für den Körperbau und die Reparatur von Gewebe benötigt werden. Eine ausreichende Aufnahme von Vitamin B6 kann dazu beitragen, Entzündungen zu reduzieren, das Risiko von Herzerkrankungen zu senken und das Immunsystem zu stärken.
Vitamin B12, auch bekannt als Cobalamin, ist ebenfalls ein wasserlösliches Vitamin, das bei der Bildung von roten Blutkörperchen und DNA eine wichtige Rolle spielt. Es ist auch wichtig für die Unterstützung des Nervensystems und des Energiestoffwechsels. Eine ausreichende Aufnahme von Vitamin B12 kann dazu beitragen, das Risiko von Anämie und neurologischen Erkrankungen zu reduzieren.
Es gibt eine Vielzahl von Nahrungsquellen, die reich an Vitamin B6 und B12 sind. Zu den besten Quellen für Vitamin B6 gehören Huhn, Fisch, Bohnen und Vollkornprodukte. Für Vitamin B12 sind tierische Produkte wie Fleisch, Eier und Milchprodukte die besten Quellen. Vegetarier und Veganer sollten sich jedoch bewusst sein, dass sie möglicherweise nicht genügend Vitamin B aus ihrer Ernährung erhalten und eventuell eine Ergänzung benötigen.
Insgesamt sind Vitamin B6 und B12 wichtige Nährstoffe, die unseren Körper unterstützen und uns helfen, gesund zu bleiben. Eine ausgewogene Ernährung, die reich Vitaminen ist, ist wichtig für eine optimale Gesundheit. Wenn Sie jedoch Bedenken bezüglich Ihrer Aufnahme von Vitamin B6 und B12 haben, sprechen Sie mit Ihrem Arzt oder Ernährungsberater, um die beste Vorgehensweise zu ermitteln.
Wir machen keine Heilversprechen und verkaufen keine Medizin!
![]() My Impulse Power Datenblatt
My Impulse Power Datenblatt
Interview mit Erhan Yilmaz


Wir durften Erhan persönlich kennenlernen und sind ihm dankbar, dass er zusammen mit seinen Partnern diese wundervollen MyImpulse Powertropfen entwickelt hat. Für uns sind sie einzigartig kraftvoll und wir glauben, dass sie noch vielen Menschen eine positive Unterstützung für ihre körperlichen Symptome sein können.
Werde MyImpulse Vertriebspartner
Als MyImpulse Vertriebspartner kannst du die Powertropfen zu günstigen Konditionen einkaufen und auch anderen Menschen die Möglichkeit bieten, Vertriebspartner zu werden. Es macht einfach Freude Informationen über Gesundheit mit anderen Menschen zu teilen.
Gerne Informieren wir Dich in einer kostenlosen Beratung. Auch per WhatsApp

Weitere Informationen
Wir kennen schon viele Menschen, die schöne Erfahrungen mit den MyImpulse Tropfen machen durften. Gerne erzählen wir dir davon. Rufe uns einfach an – auch wenn Du MyImpulse Powertropfen ausprobieren möchtest.